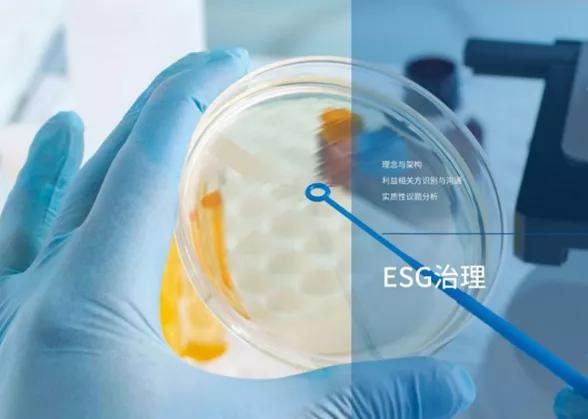

“过去的一年并不平凡,新冠病毒仍在与人类医学周旋,年中各地洪涝灾情牵动全国的关切,新一轮的医保谈判落下帷幕,集采进入常态化和制度化……
在每一个关键时刻,医药医疗行业始终坚持在护佑人民健康的第一线,为“健康中国2030”的规划不懈努力。
第二届“论健·年度星榜”(←点击查看榜单详情)有一个重要评选,正是总结了这期间中国医药医疗行业在社会责任方面的大爱担当。最终公示案例分为两类:
一是立足自身能力,贡献医疗医药产品,治病救人,谓之守土有责;
二是大步出圈,不论衣食住行哪个方面,都鼎力相助,谓之大爱无疆。
“共生·向上——第二届论健·年度星榜”之“年度企业社会责任案例”公示如下:”
守土有责·企业社会责任案例
1、GE医疗
健康新征程 关爱走基层
2021年7月11日,GE医疗中国公益支持的“健康新征程 关爱走基层”主题活动正式在北京启动。本次活动重点覆盖江西、云南、四川、贵州、青海等超过10个省份的老区和偏远地域,邀请50多位各领域专家,覆盖500多位基层医生,在一年的时间内持续开展疾病公益筛查与健康宣教、基层医师人才培训、服务和技术应用交流等公益项目,助力基层医疗卫生服务能力提升。

2、哈药集团
希望工程健康守护计划暨“哈护国苗”助力少年儿童健康成长行动
为彻底贯彻落实国家《“健康中国2030”规划纲要》,哈药集团积极响应国家号召,致力于在实施健康知识普及行动以及中小学健康促进行动中出一份力,先后捐赠了总价值1589万余元物资用于助力乡村儿童及留守儿童健康成长,并积极协同黑龙江省青基会深入乡村组织少年儿童健康讲座活动。与此同时,哈药集团正式启动希望工程健康守护计划暨“哈护国苗”助力少年儿童健康成长。

3、京东健康
京东大药房罕见病关爱中心(京东健康罕见病关爱基金)
京东健康通过上线“京东大药房罕见病关爱中心”,成立“京东健康罕见病关爱基金”,连接社会各界力量,构建“医、药、险、公益”一站式解决能力;同时,联合品牌商家共同发起公益捐赠服务模式“爱心东东”,探索实践出“多方共付”新模式,为更多有困难的患者减轻支付压力、提供一站式服务,从而助力缓解罕见病群体确诊就医难、药品可及难、药品支付难等问题。

4、镁信健康
康付·四叶草罕见病关爱中心
2021年5月,聚焦在创新支付的镁信健康把惠民保障延申到更广阔的版图。为了助力罕见病患者购药治疗的可及性,镁信健康成立了“康付·四叶草罕见病关爱中心”。
“康付·四叶草罕见病关爱中心”包括了设立罕见病专项基金;与制药及药品工业企业合作,便捷药品供给;携手全国罕见病诊疗中心,搭建多学科及远程问诊体系;携手全国专家,提供专业的罕见病教育内容;还有患者关爱、精准监测、早筛指导、心理咨询辅导、海外特许药物引进等。

5、三生国健
强直性脊柱炎健康乡村项目
脱贫攻坚期间,三生国健积极参与由原国务院扶贫办、国家卫生健康委联合实施强直性脊柱炎健康扶贫工程,面向全国832个国家级贫困县贫困强直患者开展医疗救治,帮助贫困强直患者减轻病痛。
目前,项目已在全国21个省实施,大批省市医疗专家深入一线,帮助县级医院开展救治工作,截止2021年12月底,强直性脊柱炎健康乡村项目累计筛查10784人,救治患者5505人 ,累计开展培训和义诊活动409场、培训医医护人员7509人。

6、微医
微医互联网医院“新冠肺炎实时救助平台”
2020年初至2021年底,针对疫情出现反弹的甘肃、河北、广东、黑龙江、西安等省市,平台分别推出相应疫区的“空中抗疫专区”,轻症及非发热症状的复诊患者,可通过医生开具电子处方,部分地区享受药品直接配送上门服务,最大程度降低了外出感染风险;发热相关症状患者在咨询呼吸科、感染科、内科专家后,如需要进一步去医院就诊检查,也会得到相应的科学指导,整体上减轻一线医疗机构的接诊压力。

7、西门子医疗
支援河南受灾医院重建
2021年7月,河南遭受特大暴雨并引发内涝,多家医院的影像和实验室诊断设备不同程度受损,西门子医疗积极参与到灾区医院重建中去,向河南省卫健委及受灾严重的医疗机构捐赠总价值4700万元人民币的医疗器械与技术维修服务。
与此同时,西门子医疗与受灾医院和相关机构充分沟通,具体了解医院实际需求,以确保所有救援物资物尽其用,在最需要的地方发挥其最大作用。

大爱无疆·企业社会责任案例
1、阿里健康
阿里健康“小鹿灯”儿童重疾
2021年,阿里健康联合阿里巴巴公益、中国出生缺陷干预救助基金会,上线儿童重疾救助平台,聚焦出生缺陷相关的疾病项目,为家庭困难的儿童提供从挂号到资金支持的全链路公益救助服务。
合作中,阿里健康公益联合基金会和医疗专家深入基层,与当地政府合作,通过协助基层干部拉网式排查、为患儿提供义诊、对接优质医疗资源、医疗救助、经济帮扶活动。
除此之外,平台二期在原有救助基础上,对救助儿童的病种和覆盖区域做了拓展,联合中国社会福利基金会,继续推进主动救助的模式,对包括白血病、恶性肿瘤这些后天罹患重疾患儿提供救助。项目上线后,近半年已在9省11县陆续启动,覆盖91个乡镇。

2、北海康成
“黏在一起 遇见未来” MPSII全国患者赋能培训项目
2021年,北京正宇黏多糖罕见病中心及北京病痛挑战基金会主办,北海康成制药有限公司公益支持的“黏在一起,遇见未来” MPSII全国患者赋能培训项目在北京、杭州、广州、济南等地开展,共赋能近百个家庭。
该活动辅助患者在诊疗提升、用药可及的倡导层面通过有效的方式进行发声、传递诉求。在赋能培训的帮助下,来自全国约15个省份的患者形成区域团队,充分与区域内的利益相关方进行沟通,从患者组织层面为提升MPSII疾病认知度以及展示患者为满足的需求做出了巨大的推动。

3、百洋医药
尊医重卫,大爱无疆
自2005年起,百洋医药集团与中国医师协会共同发起成立“中国医师道德建设与法律援助百洋基金“,为期20年,用于医师的人文素质教育、法律知识培训、典型侵权个案的法律援助以及协会活动的展开。

4、辉瑞生物制药集团
“为爱出发”志愿服务公益行
辉瑞中国支持员工服务社区,为开展志愿服务搭建平台,履行社会责任,发挥无私奉献的志愿服务精神!辉瑞“为爱出发”志愿服务公益行至今已推行了九年。
2021年,“为爱出发”云支教项目通过在线授课的方式,为4省9市的10所乡村小学奉献了40堂精彩的运动与健康课程,209位低年级乡村学生直接获益。

5、礼来中国
驰援河南灾后重建
2021年7月,河南遭遇的极端特大暴雨以及由此引发的洪涝灾害造成了重大的人员和经济损失。为了向河南群众以及医疗机构提供力所能及的帮助,礼来中国通过向中国红十字基金会捐赠费用,用于受灾严重医院医疗物资采购、灾情相关疾病卫生管理、灾后防疫等工作。

6、平安健康
精诚奖——2021首届医生科普大赛(上海)
2021年,由上海市卫生健康委员会、上海市健康促进委员会办公室共同指导,上海市医药卫生发展基金会、上海市健康促进中心联合主办的“精诚奖——2021首届医生科普大赛(上海)”活动展开,平安健康对此提供特别支持,用短视频+医学科普+公益的“混搭”,让医学科普更“接地气”,推动科普事业发展、提升国民健康素养。
活动有近2000名公立医院医生参赛,累计投票182.6万。同时,平安健康按照“一次点击、一分爱心”的规则,将点赞数量换算成现金,最终以全体参赛者的名义定向捐赠给上海市医药卫生发展基金会300万,用于医学科普事业的发展,让市民更好地享受有温度的健康关怀,打造高品质健康生活。

7、锐翌生物
“抗汛救灾 青春护航”关爱行动
2021年7月份,河南多地遭遇强降水天气,灾情严重。对此,锐翌生物积极参与“抗汛救灾 青春护航”关爱行动,向河南卫辉灾区积极捐赠救急物资,首批救急物资包括大功率防汛泵、消毒原液、方便面等必需物资品,为受灾群众和抢险人员提供生活保障。

8、药明康德
环境、社会及管制被MSCI评为AA级
2021年9月,在摩根士丹利资本国际公司(MSCI)最新的“环境、社会及企业管治”(ESG)年度评级结果中,药明康德ESG评级提升至AA级,其中“公司治理”和“产品安全与质量”两项指标表现突出。药明康德重视ESG管理的各个环节,提升包括产品安全与质量、环境保护、企业社会责任等在内的ESG相关工作,将环境和社会责任融入公司战略和运营。
9、再鼎医药
“每一秒都值得守护”脑胶质瘤关爱之家
为呼吁患者勇敢面对疾病、建立积极治疗的抗癌信心,由中国初级卫生保健基金会主办,再鼎医药支持的“爱普新生-脑胶质瘤患者关爱之家”患者交流分享会在全国各地热烈举办。该活动首次将世界胶质母细胞瘤关注日带入中国,希望通过互助交流平台的搭建,汇聚社会多方之力,共筑脑胶质瘤关爱生态圈,为中国脑胶质瘤患者家庭提供关怀与支持。

本文来源:健识局 作者:小编 免责声明:该文章版权归原作者所有,仅代表作者观点,转载目的在于传递更多信息,并不代表“医药行”认同其观点和对其真实性负责。如涉及作品内容、版权和其他问题,请在30日内与我们联系
 健识局
健识局


 我们沟通的很顺畅
我们沟通的很顺畅 电话已拨通,无人接听
电话已拨通,无人接听 这个电话号码是空号
这个电话号码是空号